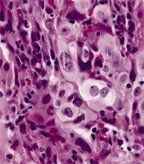

In patients with advanced NSCLC and without any mutation in the EGFR gene, docetaxel provides significantly improved progression-free survival compared to erlotinib, according to a phase III randomized trial.
In patients with advanced non–small-cell lung cancer (NSCLC) and without any mutation in the EGFR gene, docetaxel provides significantly improved progression-free survival compared to erlotinib (Tarceva), according to a phase III randomized trial. And importantly, a common gene mutation was not seen to play any prognostic role in these patients.
Large-cell carcinoma of the lung
“TAILOR does not support the use of erlotinib over docetaxel in patients with EGFR wild-type,” said lead investigator Marina Garassino, MD, of Fatebenefratelli Hospital in Milan, Italy.
Erlotinib, an EGFR tyrosine kinase inhibitor, has proven to be an effective agent in patients with mutations in the EGFR gene, but its efficacy in wild-type EGFR patients was unclear. In the TAILOR study, investigators randomized patients to either erlotinib 150 mg/day or chemotherapy with docetaxel 75 mg/m2 or 35 mg/m2. Of 702 patients registered, 554 were genotyped, 222 were randomized, and 219 were eligible for the final analysis (110 docetaxel patients, 109 erlotinib patients).
Docetaxel proved significantly more effective than erlotinib. The hazard ratio for progression-free survival was 0.69 in favor of docetaxel (95% CI, 0.52–0.93; P = .014). For both populations, though, disease prognosis remains poor: the median progression-free survival for docetaxel-treated patients was 3.4 months, compared with 2.4 months for erlotinib. A total of 28.9% of patients receiving docetaxel had not progressed after 6 months, compared with 16.9% of erlotinib patients.
On multivariate analysis, only ECOG performance status of 2 (vs 0 or 1) and treatment arm were predictive of progression-free survival. The HR for progression for docetaxel vs. erlotinib was 0.70 (P = .019). Interestingly, KRAS status was not predictive of outcome.
“The TAILOR study draws out attention to the fact that outcomes are poor in second-line treatment of non–small-cell lung cancer, with our available treatments resulting in median progression-free survivals of two or three months,” said Benjamin Solomon, MBBS, PhD, of Peter MacCallum Cancer Centre in Melbourne. “We really need better treatments, but we also need to use our existing treatments in the best way possible.” Dr. Solomon was not involved with the TAILOR trial.
The median age of patients was similar between the two groups, at 67 in the docetaxel group and 66 in the erlotinib group. About two-thirds of both groups were male, and more than 90% of both groups was made up of patients with a performance status of 0 or 1. Almost 72% of docetaxel patients were current or former smokers, compared with 81.7% in the erlotinib group. Mutated KRAS status was present in 22.7% of docetaxel patients and 23.9% of erlotinib patients.
Garassino said the adverse events in the trial were consistent with other published studies involving these drugs. A total of 27% of docetaxel patients had grade 3 or 4 neutropenia, and 29% had alopecia of any grade; 14% of erlotinib patients suffered grade 3 or 4 dermatological toxicities. There was one treatment-related death in the erlotinib group, and 22.1% of docetaxel patients and 29.0% of erlotinib patients suffered adverse events that led to dose modification.